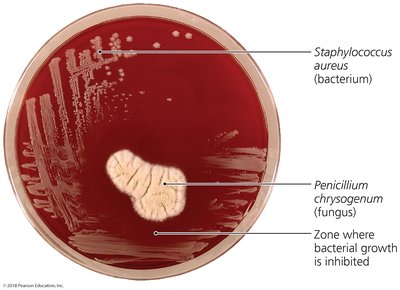
Antibiotic effect of Penicillium chrysogenum
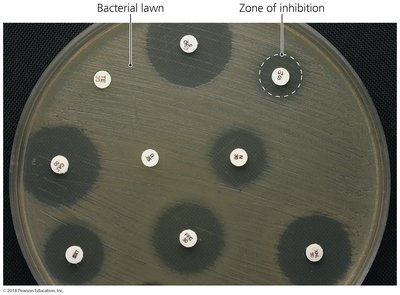
Zones of inhibition in a diffusion susceptibility test

Back
BackControlling Microbial Growth in the Body: Antimicrobial Drugs
Study Guide - Smart Notes

Controlling Microbial Growth in the Body: Antimicrobial Drugs
The History and Types of Antimicrobial Agents
Antimicrobial drugs are essential tools in modern medicine for treating infections and controlling microbial growth within the body. Their development and classification are rooted in their origin and chemical structure.
Drugs: Chemicals that affect physiology in any manner.
Chemotherapeutic agents: Drugs that act against diseases.
Antimicrobial agents (antimicrobials): Drugs that treat infections.
Antibiotics: Antimicrobial agents produced naturally by organisms.
Semisynthetics: Chemically altered antibiotics that are more effective, longer lasting, or easier to administer than naturally occurring ones.
Synthetics: Antimicrobials that are completely synthesized in a laboratory.
Example: Penicillium chrysogenum produces penicillin, which inhibits the growth of Staphylococcus aureus.
Table: Sources of Common Antibiotics and Semisynthetics
This table summarizes the microorganisms that produce various antibiotics and semisynthetic drugs.
Microorganism | Antimicrobial |
|---|---|
Penicillium chrysogenum (Fungi) | Penicillin G |
Penicillium griseofulvum (Fungi) | Griseofulvin |
Acremonium spp.* (Fungi) | Cephalothin |
Streptomyces griseus (Bacteria) | Streptomycin |
Bacillus polymyxa (Bacteria) | Polymyxin |
Streptomyces venezuelae (Bacteria) | Chloramphenicol |
Streptomyces nodosus (Bacteria) | Amphotericin B |
Streptomyces avermitilis (Bacteria) | Ivermectin |
Additional info: See original table for more entries. |

Mechanisms of Antimicrobial Action
Antimicrobial drugs act through several distinct mechanisms, targeting specific structures or processes in microbial cells. Successful chemotherapy requires selective toxicity, meaning the drug harms the pathogen more than the host.
Inhibition of cell wall synthesis
Inhibition of protein synthesis
Disruption of cytoplasmic membranes
Inhibition of metabolic pathways
Inhibition of nucleic acid synthesis
Prevention of pathogen's attachment or entry into host cell

Inhibition of Cell Wall Synthesis
Many antibacterial drugs target the synthesis of bacterial cell walls, which are composed of peptidoglycan. The most common agents prevent cross-linkage of NAM (N-acetylmuramic acid) subunits, weakening the cell wall and causing cell lysis.
Beta-lactams: Bind to enzymes that cross-link NAM subunits. Their functional group is the beta-lactam ring.
Semisynthetic derivatives: More stable, better absorbed, less susceptible to deactivation, and more active against a broader range of bacteria.
Vancomycin: Interferes with bridges linking NAM subunits in Gram-positive bacteria.
Bacitracin: Blocks transport of NAG (N-acetylglucosamine) and NAM from cytoplasm.
Isoniazid and ethambutol: Disrupt mycolic acid formation in mycobacterial species.
Example: Beta-lactam antibiotics inhibit cell wall synthesis, leading to cell lysis.



Inhibition of Protein Synthesis
Antimicrobial drugs can interfere with protein synthesis by targeting prokaryotic ribosomes, which are structurally different from eukaryotic ribosomes. This allows selective targeting of bacterial cells.
Prokaryotic ribosomes: 70S (30S and 50S subunits)
Eukaryotic ribosomes: 80S (40S and 60S subunits)
Drugs: Can selectively inhibit translation in bacteria, but may affect mitochondria in humans due to their 70S ribosomes.

Disruption of Cytoplasmic Membranes
Some drugs damage the integrity of cytoplasmic membranes by forming channels, leading to cell death. This mechanism is especially important in antifungal therapy.
Nystatin and amphotericin B: Attach to ergosterol in fungal membranes, forming pores.
Humans: Somewhat susceptible due to cholesterol similarity to ergosterol.
Bacteria: Lack sterols and are not susceptible to these drugs.

Inhibition of Metabolic Pathways
Antimetabolic agents are effective when pathogen and host metabolic processes differ. These drugs block key steps in metabolic pathways, such as folic acid synthesis.
Atovaquone: Interferes with electron transport in protozoa and fungi.
Heavy metals: Inactivate enzymes.
Agents: Disrupt tubulin polymerization and glucose uptake in protozoa and worms.
Sulfonamides: Inhibit folic acid synthesis by acting as metabolic antagonists.

Inhibition of Nucleic Acid Synthesis
Several drugs block DNA replication or RNA transcription, often affecting both eukaryotic and prokaryotic cells. These are mainly used in research or to slow cancer cell replication.
Quinolones and fluoroquinolones: Act against prokaryotic DNA gyrase.
Nucleotide/nucleoside analogs: Interfere with nucleic acid function, distorting shapes and preventing replication, transcription, or translation.
Reverse transcriptase inhibitors: Target HIV replication; do not harm humans as they lack reverse transcriptase.
Prevention of Virus Attachment, Entry, or Uncoating
Attachment antagonists block viral attachment or receptor proteins, preventing infection. This is a new area of antimicrobial drug development.
Pleconaril: Blocks viral attachment.
Arildone: Prevents viral uncoating.
Clinical Considerations in Prescribing Antimicrobial Drugs
Spectrum of Action
The spectrum of action refers to the number of different pathogens a drug acts against. Narrow-spectrum drugs are effective against few organisms, while broad-spectrum drugs target many.
Broad-spectrum drugs: May allow for secondary or superinfections by killing normal flora and reducing microbial antagonism.

Effectiveness
Effectiveness of antimicrobial drugs is determined by laboratory tests:
Diffusion susceptibility test (Kirby-Bauer): Measures zone of inhibition.
Minimum inhibitory concentration (MIC) test: Determines lowest concentration that inhibits growth.
Minimum bactericidal concentration (MBC) test: Determines lowest concentration that kills bacteria.

Routes of Administration
Antimicrobial drugs can be administered in several ways, affecting their distribution and effectiveness:
Topical: For external infections.
Oral: Self-administered, no needles.
Intramuscular: Delivered via needle into muscle.
Intravenous: Delivered directly to bloodstream.

Safety and Side Effects
Safety is a major consideration in prescribing antimicrobial drugs. Toxicity, allergies, and disruption of normal microbiota are important factors.
Toxicity: May affect kidneys, liver, or nerves; special consideration for pregnant women.
Allergies: Rare but can be life-threatening (anaphylactic shock).
Disruption of normal microbiota: May result in secondary infections or superinfections, especially in hospitalized patients.

Resistance to Antimicrobial Drugs
The Development of Resistance in Populations
Some pathogens are naturally resistant, while others acquire resistance through mutations or by obtaining resistance genes (R plasmids) via transformation, transduction, or conjugation.
New mutations: Change chromosomal genes.
Acquisition of R plasmids: Horizontal gene transfer mechanisms.

Mechanisms of Resistance
Bacteria can resist antimicrobial drugs through several mechanisms:
Enzyme production: Destroys or deactivates drug (e.g., beta-lactamase).
Prevent entry: Slow or prevent drug entry into cell.
Alter target: Change drug target so it binds less effectively.
Alter metabolism: Change metabolic chemistry.
Efflux pumps: Pump drug out of cell before it can act.
Biofilms: Bacteria in biofilms resist antimicrobials.
MfpA protein: Mycobacterium tuberculosis binds DNA gyrase, preventing fluoroquinolone binding.

Multiple Resistance and Cross Resistance
Pathogens can acquire resistance to multiple drugs, especially in hospital settings where R plasmids are exchanged. Multiple-drug-resistant pathogens are resistant to at least three antimicrobial agents. Cross resistance occurs when drugs are similar in structure.

Retarding Resistance
Strategies to slow the development of resistance include:
Maintain high drug concentration: Inhibit pathogen so immune system can eliminate it.
Use combination therapy: Synergism enhances effect; antagonism interferes.
Use antimicrobials only when necessary.
Develop new drugs: Second- and third-generation drugs, bacteriocins, and drugs designed to fit microbial proteins.

Additional info: Resistance is a population-level phenomenon; individual bacteria do not develop resistance in response to antibiotics, but resistant mutants are selected for and proliferate.
